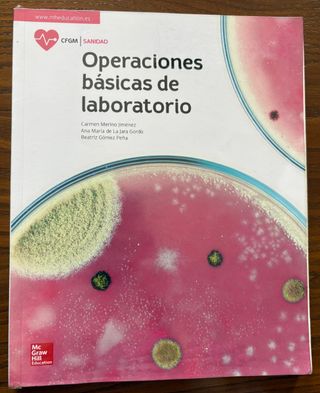

Libros, música y películas de segunda mano Tordesillas
Novedades
Economía, Emprendimiento y Actividad empresaria...
Libro de economía emprendimiento, y actividad empresarial para primero de bachillerato , en muy buenas condiciones en el interior , está prácticamente nuevo … hago envíos muy rápidos #libros #librosbachillerato #economia ##libroeconomia
Economía 1.
Libro de economía para primero de bachillerato , en muy buenas condiciones en el interior , está prácticamente nuevo … hago envíos muy rápidos #libros #librosbachillerato #economia ##libroeconomia
Estrella roja (Spanish Edition)
Libro Estrella Roja de Alexander Bogdánov Tapa blanda En perfecto estado

Itinerario personal para la empleabilidad I 360°
LIBRO DE APRENDIZAJE EN BUEN ESTADO

Atención y apoyo psicosocial.
LIBRO DE ENSEÑANZA EN BUEN ESTADO
A qué sabe España Directo
como nuevo
Las recetas dukan (OTROS NO FICCIÓN) (Spanish E...
perfecto estado
English File
Se vende libro English File B1

El Valle de los Leones (Spanish Edition)
Libro El Valle de los Leones de Ken Follet Tamaño bolsillo Tapa blanda
Entradas coleccionables Superman y Capitán América
Lote de cuatro entradas de cine coleccionables. - Dos entradas de Capitán América: Brave New World. - Dos entradas de Superman (película de James Gunn). - Ambas entradas son de la colección de Marvel Studios y DC Studios.
One Punch-Man 01
En muy buen estado, vendo todos por 26 y cada uno por separado a 4

Haikyû!! nº 01
Estan en muy buen estado Vendo cada unidad a 4 y los 4 a 12
¿Qué me quieres, amor?
Libro, ¿Qué me quieres, amor? de Manuel Rivas Libro que inspiró la película La lengua de las mariposas De bolsillo Tapa blanda
Biología y Geología 3 ESO ANAYA
Completamente nuevo
Dominoes, New Edition: Level 2: 700-Word Vocabu...
nuevo
La canción de Shao Li (EXIT) (Spanish Edition)
nuevo
Princesas Dragón 12: La corona del cuervo
nuevo , sin leer
cuaderno nuevo sin usar
sin estrenar
El quarterback que me lio
nuevo . no leído .
Las reglas del juego
libro de romance
Nuevo Testamento
como nuevo
Réplica Katana Zenitsu Kimetsu no Yaiba
Réplica de la katana de Zenitsu Agatsuma, personaje de la popular serie Kimetsu no Yaiba. - Hoja blanca curva. - Empuñadura blanca con detalles amarillos. - Guarda dorada. - Tapa dorada en el extremo superior. Preferible entreg en mano para poder ver Y evitardaños de transporte
Libro operaciones básicas de laboratorio
Libro operaciones básicas de laboratorio de Mc Graw Hill
Libro empresa e iniciativa emprendedora
Libro empresa e iniciativa emprendedora de tu libro de FP
Libro oficina de farmacia Mc Graw Hill
Libro oficina de farmacia de Mc Graw Hill
Dispensación de productos farmacéuticos
Dispensación de productos farmacéuticos de Mc Graw Hill
Libro formulación magistral paraninfo
Libro formulación magistral de paraninfo
Trilogia La Profecia deMerlin, Batalla de Reyes...
Los tres libros de la saga de este escritor sobre Merlin. Te encantará. - Batalla de Reyes. - Muerte de un imperio. - Red de Traiciones. REBAJADO SOLO ESTE FIN DE SEMANA! En tapa dura y con sobrecubierta. Precio en librerias: 42 euros
La muñeca de porcelana
Libro como nuevo. Precio en tienda: 20,90 euros. Haz tu propio lote en mi perfil y ahorra en gastos

Victor Jara - Te Recuerdo Amanda LP
Disco de vinilo de Victor Jara, el álbum "Te Recuerdo Amanda". Es un disco en buen estado. ENVIO POR CORREOS!!! Victor Jara - Te Recuerdo Amanda; 1986 – Spain Vinilo, LP, Compilation, Reissue Fonomusic – 84.2490/9 ENVIO POR CORREOS!!! - Álbum: Te Recuerdo Amanda - Artista: Victor Jara - Formato: Vinilo LP
Strange
Vendo cómics Francés Strange unos 200 numéros, fotos disponibles
Five Feet Apart
Leído una vez

Teclado Musical YM-228B
Teclado musical con varias funciones y sonidos. - 2 Timbres - 4 Percusiones - 10 canciones de demostración - Modos de guía - Grabación y reproducción - Control de volumen - Entrada para micrófono externo - Entrada para altavoz externo - Control de tempo

Teclado Casio PT-1
Teclado electrónico musical Casio PT-1. - Diseño compacto y portátil. - Teclas blancas y negras. - Altavoz integrado.

Libros Cocina
Se venden libros de cocina
Introducción al Derecho
Libro utilizado alguna vez y con alguna anotación en lápiz. Tiene un pequeño defecto en la parte inferior

La caza en la gastronomía
La Caza en la Gastronomia

La Cocina magistral
La Cocina Magistral: Lo mejor de restauradores

Atlas De Los Hongos De Castilla Y León
Atlas de los Hongos de Castilla y Leon
Diccionario ilustrado de la lengua española
Diccionario ilustrado de la lengua española de 1971
CINCUENTA SOMBRAS DE GREY
Leído una vez
Literatura Universal Bachillerato (2009)
Libro de literatura universal de 2 de bachillerato. Algunas de las páginas están subrayadas con colores o escritas a lapiz. Viene incluido un DVD

Ciudades de papel
Leído una vez
Cinta Cassete Camarón - Caminando
Cinta de cassette del artista Camarón de la Isla. - Título del álbum: Caminando - Incluye la canción Soy Gitano - Versión Original - Formato: Stereo - Sistema de sonido: Dolby System
Cinta Cassete U2 War
Cinta de cassette del álbum War de U2. - Álbum de estudio. - Formato de cinta de cassette.
Cinta Cassete Los Chichos Noches de Barcelona
Cinta de cassette del grupo Los Chichos. - Título: Noches de Barcelona - Versión Original - Formato: Stereo - Incluye Dolby System
Cinta Cassete Los Chichos - Flamenco
Cinta de casete del grupo Los Chichos. - Títulos incluidos: Has Tenido Mil Amores, Perversa y otros. - Versión Original.
Langenscheidt Diccionario Básico Alemán
Sin usar
Diccionario Oxford Pocket para estudiantes
El CD no viene incluido
Cinta Cassete Tina Turner Break Every Rule
Cinta de cassette de Tina Turner. - Álbum: Break Every Rule.
Por trece razones
No se ha leído nunca

Micrófono USB
Micrófono USB en perfecto estado, ideal para usar con tu ordenador. - Micrófono de color negro. - Conexión USB. - Cable USB incluido.
PACK 4 libros GERONIMO STILTON
perfectos

El violín del diablo (Spanish Edition)
perfecto

FINIS MUNDI
perfecto

La décima sinfonía
perfecto

Hoyos
perfecto

RICARDO CORAZÓN DE CARDO
perfecto

El pequeño Nicolás
perfecto

Memorias de Tristán Saldaña
perfecto

ERIK VOGLER Y LOS CRÍMENES DEL REY BLANCO
perfecto

El Músico: Novela negra policíaca y de fantasía...
perfecto

Mitos Griegos (cucaa) (Cucana) (Spanish Edition)
perfecto

El Jorobado Y Otros Cuentos de las 1001 noches
perfecto

Sexto viaje al Reino de la Fantasía: ¡Descubre ...
perfecto

El chico de la última fila: con un ensayo de Ca...
perfecto

Las Lágrimas de Shiva (Periscopio/ Periscope) (...
perfecto

DESCONOCIDOS: Premio EDEBÉ de Literatura Juveni...
perfecto

PREMIO EDEBÉ 2015: Mentira (Spanish Edition)
perfecto

El chico de la flecha (Spanish Edition)
perfecto

CINCO Y EL TESORO DE LA ISLA - LOS
perfecto

El conde Lucanor, ESO. Material auxiliar (Spani...
perfecto

Tom Sawyer (Spanish Edition)
perfecto

101 lugares míticos del rock
perfecto estado
Pack edición 7 libros MONDRAGO
Pack de los 7 libros de Mondrago
Pack 6 libros en inglés
perfectos, 10 euros todos o 4 euros cada uno